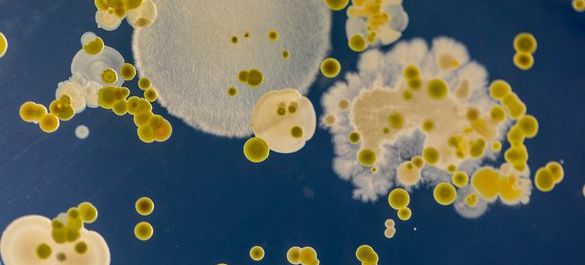
Soil-sample-iStock-Sinhyu.jpg

Press and media
The Microbiology Society is a membership charity for scientists interested in microbes, their effects and their practical uses. It is one of the largest microbiology societies in Europe with a worldwide membership based in universities, industry, hospitals, research institutes and schools.
Media enquiries
Our members have a unique breadth and depth of knowledge about the wide-ranging discipline of microbiology. We can help you tell your story by putting you in contact with a relevant expert.
For media enquiries please contact us at press@microbiologysociety.org.
This inbox is monitored from 9am to 5pm Monday to Friday.
View our latest press releases
-
Press releases
Press releases published by the Microbiology Society.
View our media guides
Quick and simple guides for safely communicating key concepts in microbiology in the media, created in collaboration with our expert membership.